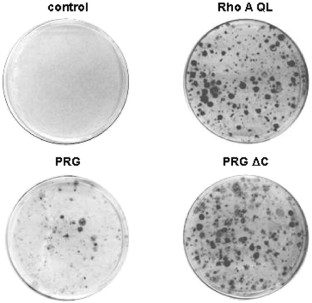

Abstract
PDZ-RhoGEF, LARG, and p115RhoGEF are members of a newly identified family of Rho-guanine nucleotide exchange factors (GEFs) exhibiting a unique structural feature consisting of the presence of an area of similarity to regulators of G protein signaling (RGS). This RGS-like (RGL) domain provides a functional motif by which Gα12 and Gα13 can bind and regulate the activity of these RhoGEFs, thus providing a direct link from these heterotrimeric G proteins to Rho. PDZ-RhoGEF and LARG can also be phosphorylated by tyrosine kinases, including FAK, and associate with Plexin B, a semaphorin receptor, which controls axon guidance during development, through their PDZ domain, thereby stimulating Rho. Interestingly, while characterizing a PDZ-RhoGEF antiserum, we found that a transfected PDZ-RhoGEF construct associated with the endogenous PDZ-RhoGEF. Indeed, we observed that PDZ-RhoGEF and LARG can form homo- and hetero-oligomers, whereas p115RhoGEF can only homo-oligomerize, and that this intermolecular interaction was mediated by their unique C-terminal regions. Deletion of the C-terminal tail of PDZ-RhoGEF had no significant effect on the GEF catalytic activity towards Rho in vitro, but resulted in a drastic increase in the ability to stimulate a serum response element reporter and the accumulation of the GTP-bound Rho in vivo. Furthermore, removal of the C-termini of each of the three RGL-containing GEFs unleashed their full transforming potential. Together, these findings suggest the existence of a novel mechanism controlling the activity of PDZ-RhoGEF, LARG, and p115RhoGEF, which involves homo- and hetero-oligomerization through their inhibitory C-terminal region.
This is a preview of subscription content, access via your institution
Access options
Subscribe to this journal
Receive 50 print issues and online access
$259.00 per year
only $5.18 per issue
Buy this article
- Purchase on SpringerLink
- Instant access to the full article PDF.
USD 39.95
Prices may be subject to local taxes which are calculated during checkout

Similar content being viewed by others
References
Aghazadeh B, Lowry WE, Huang XY and Rosen MK . (2000). Cell, 102, 625–633.
Anborgh PH, Qian X, Papageorge AG, Vass WC, DeClue JE and Lowy DR . (1999). Mol. Cell. Biol., 19, 4611–4622.
Aurandt J, Vikis HG, Gutkind JS, Ahn N and Guan KL . (2002). Proc. Natl. Acad. Sci. USA, 99, 12085–12090.
Bustelo XR . (2000). Mol. Cell. Biol., 20, 1461–1477.
Cerione RA and Zheng Y . (1996). Curr. Opin. Cell Biol., 8, 216–222.
Chikumi H, Fukuhara S and Gutkind JS . (2002). J. Biol. Chem., 277, 12463–12473.
Crespo P, Schuebel KE, Ostrom AA, Gutkind JS and Bustelo XR . (1997). Nature, 385, 169–172.
Fukuhara S, Chikumi H and Gutkind JS . (2000). FEBS Lett., 485, 183–188.
Fukuhara S, Chikumi H and Gutkind JS . (2001). Oncogene, 20, 1661–1668.
Fukuhara S, Murga C, Zohar M, Igishi T and Gutkind JS . (1999). J. Biol. Chem., 274, 5868–5879.
Han J, Luby-Phelps K, Das B, Shu X, Xia Y, Mosteller RD, Krishna UM, Falck JR, White MA and Broek D . (1998). Science, 279, 558–560.
Hart MJ, Eva A, Zangrilli D, Aaronson SA, Evans T, Cerione RA and Zheng Y . (1994). J. Biol. Chem., 269, 62–65.
Hart MJ, Jiang X, Kozasa T, Roscoe W, Singer WD, Gilman AG, Sternweis PC and Bollag G . (1998). Science, 280, 2112–2114.
Hill CS, Wynne J and Treisman R . (1995). Cell, 81, 1159–1170.
Kim S, Lee SH and Park D . (2001). J. Biol. Chem., 276, 10581–10584.
Kozasa T, Jiang X, Hart MJ, Sternweis PM, Singer WD, Gilman AG, Bollag G and Sternweis PC . (1998). Science, 280, 2109–2111.
Lambert JM, Lambert QT, Reuther GW, Malliri A, Siderovski DP, Sondek J, Collard JG and Der CJ . (2002). Nat. Cell Biol., 4, 621–625.
Longenecker KL, Lewis ME, Chikumi H, Gutkind JS and Derewenda ZS . (2001). Structure (Camb), 9, 559–569.
Nimnual AS, Yatsula BA and Bar-Sagi D . (1998). Science, 279, 560–563.
Perrot V, Vazquez-Prado J and Gutkind JS . (2002). J. Biol. Chem., 277, 43115–43120.
Ponting CP . (1999). J. Mol. Med., 77, 695–698.
Reid T, Furuyashiki T, Ishizaki T, Watanabe G, Watanabe N, Fujisawa K, Morii N, Madaule P and Narumiya S . (1996). J. Biol. Chem., 271, 13556–13560.
Ren XD, Kiosses WB and Schwartz MA . (1999). EMBO J., 18, 578–585.
Ridley AJ and Hall A . (1992). Cell, 70, 389–399.
Russo C, Gao Y, Mancini P, Vanni C, Porotto M, Falasca M, Torrisi MR, Zheng Y and Eva A . (2001). J. Biol. Chem., 276, 19524–19531.
Sakabe K, Teramoto H, Zohar M, Behbahani B, Miyazaki H, Chikumi H and Gutkind JS . (2002). FEBS Lett., 511, 15–20.
Schmidt A and Hall A . (2002). Genes Dev., 16, 1587–1609.
Shi CS, Sinnarajah S, Cho H, Kozasa T and Kehrl JH . (2000). J. Biol. Chem., 275, 24470–24476.
Swiercz JM, Kuner R, Behrens J and Offermanns S . (2002). Neuron, 35, 51–63.
Takai Y, Sasaki T and Matozaki T . (2001). Physiol. Rev., 81, 153–208.
Taya S, Inagaki N, Sengiku H, Makino H, Iwamatsu A, Urakawa I, Nagao K, Kataoka S and Kaibuchi K . (2001). J. Cell Biol., 155, 809–820.
Teramoto H, Salem P, Robbins KC, Bustelo XR and Gutkind JS . (1997). J. Biol. Chem., 272, 10751–10755.
Whitehead IP, Campbell S, Rossman KL and Der CJ . (1997). Biochim. Biophys. Acta, 1332, F1–F23.
Zheng Y . (2001). Trends Biochem. Sci., 26, 724–732.
Zhu K, Debreceni B, Bi F and Zheng Y . (2001). Mol. Cell. Biol., 21, 425–437.
Zohar M, Teramoto H, Katz BZ, Yamada KM and Gutkind JS . (1998). Oncogene, 17, 991–998.
Author information
Authors and Affiliations
Corresponding author
Additional information
This article is a ‘United States Government Work’ paper as defined by the US Copyright Act
Rights and permissions
About this article
Cite this article
Chikumi, H., Barac, A., Behbahani, B. et al. Homo- and hetero-oligomerization of PDZ-RhoGEF, LARG and p115RhoGEF by their C-terminal region regulates their in vivo Rho GEF activity and transforming potential. Oncogene 23, 233–240 (2004). https://doi.org/10.1038/sj.onc.1207012
Received:
Revised:
Accepted:
Published:
Issue date:
DOI: https://doi.org/10.1038/sj.onc.1207012
Keywords
This article is cited by
-
Rho GTPase activity crosstalk mediated by Arhgef11 and Arhgef12 coordinates cell protrusion-retraction cycles
Nature Communications (2023)
-
Systems analysis of RhoGEF and RhoGAP regulatory proteins reveals spatially organized RAC1 signalling from integrin adhesions
Nature Cell Biology (2020)
-
Assembly and activation of the Hippo signalome by FAT1 tumor suppressor
Nature Communications (2018)
-
Regulating Rho GTPases and their regulators
Nature Reviews Molecular Cell Biology (2016)
-
Endothelin A receptor drives invadopodia function and cell motility through the β-arrestin/PDZ-RhoGEF pathway in ovarian carcinoma
Oncogene (2016)



